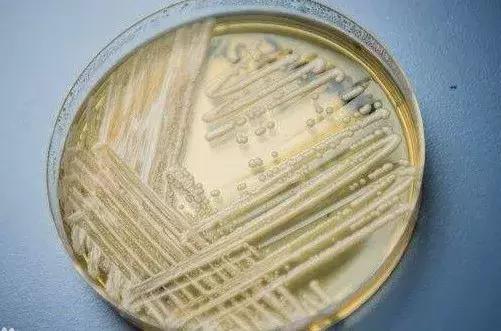
超级真菌致死率高达60%,致死率高达60%的超级真菌

前段时间,“中国确诊18例超级真菌感染”的新闻被刷上热搜,身边的闺蜜群家人群纷纷转载起了相关信息,让人心头一紧。

“超级真菌”的真名叫做耳念珠菌,是一种具有超强耐药性、高达60%血液感染死亡率的真菌。
超级真菌是个啥?为什么突然一夜爆发?
之所以称之为“超级”,一是耳念珠菌的耐药性很强,像临床常用的三大类抗真菌药,几乎无法抵抗这部分耳念珠菌的侵害;二是以它的生存时间长,即使患者不幸死亡,耳念珠菌还是能够长期存活在患者、医护人员的皮肤上,或者是医院设施表面。
事实上,它也并不是“一夜爆红”,早在2018年5月,中国的医学研究团队就曾公布过中国首例“超级真菌”感染病例,只不过因为病例少,处理恰当及时,也就没有过多曝光。(消息来源:北京大学医学部)
“超级真菌”先是在美国爆发,目前全美感染病例已上升到500多宗,将近一半的感染者在3个月内身亡。随后病菌开始蔓延到30多个国家。而在中国大陆,目前共确认了18例。

很多人看完后感到一阵莫名恐慌,总觉得自己可能被感染了。毕竟被感染初期的症状和感冒很相似,发烧、疼痛、疲劳;不同的是,“超级真菌”最终的症状,是器官衰竭。
什么样的人容易被“超级真菌”感染?
感染“超级真菌”的人群一般以下四类:
1. 长期住院的病人;免疫力低,接触的病原体多
2. 长期使用广谱抗生素和抗真菌药物的人群;人体对真菌已经免疫了
3. 使用呼吸管、饲管、膀胱导管住院的病人;细菌接触面大,自身免疫低
4. 免疫系统缺陷的病人
文章开头提到,耳念珠菌会长时间“寄居”在曾经待过的地方,所以说,这种真菌更容易在医院环境中传播,尤其是ICU病房。

也就是说,长期在医院里的、并且不注重卫生的人,被感染的概率更大。
而非易感人群,也就是普通健康人,不必太敏感。
在查阅相关资料的时候,我发现早在2009年,有研究者在一名日本患者的耳道分泌物中发现这种耳念珠菌,并将它定义为一种院内感染菌。
怎样避免“超级真菌”的感染?
对于普通健康人来说,“超级真菌”并没有太大的影响。但是,免疫力极度低下的人群还是容易感染。除了长期处于医院环境下的病人,像体弱的老年人、新生儿或者术后患者也需要引起一定的注意。

相信大家已经能够推测出如日常防护了吧?来,咱们一起划重点:
- 不乱用抗生素、抗真菌药,服药期间一定要遵医嘱服药
- 日常生活要保持良好的卫生。尤其是在医院待过,一定要及时洗浴和换洗衣物
- 增强抵抗力——优先食补+运动,其次才是通过辅助保健品达到目的
那么今天,澳范儿就先给大家打个预防针,推荐几类辅助提高人体免疫力的产品,防患于未然。
维 C
每年一到换季,就开始了一场人体自身免疫力对抗外界病菌的battle,尤其是这段时间,国内气温的浮动只能用一个词来形容:满30减15。
虽然国内的人常说:感冒吃药5天好,不吃药7天好。但似乎这句老话被更多用在澳洲人身上。澳洲的医生很“好当”,不管你感冒有多严重,医生只会叮嘱你“多喝水”,实在熬不住了,就吃点止痛药片panadol。

所以对于澳洲人来说,预防大于治疗。
而维C,就是一种成本低,效果好的提高免疫力的物质。

维C之所以能预防感冒,实际上是因为维C可以增强机体对外界环境的抗应激能力,从而提升机体免疫力。
但是要注意的是,人体是无法自发分泌维C的,并且维C的水溶性,导致它挥发流失的速度非常快。因此,阶段性地保持补充维C就很有必要了。
市面上的维C补充剂有三种:溶水性的泡腾片、直接吃的咀嚼片或软糖、吞服的维C片。

比较下来,我个人更偏向咀嚼片。吃起来比较方便,而且由于咀嚼片是融合的维生素C的多种形式,是一种缓释型低酸度,对胃的刺激比较小。
Blackmores维C咀嚼片是一个不错的选择。它的维生素C含量高,每片含500mg 高含量维生素C,一片相当于6颗橙子的维C含量;还额外添加了柑橘生物类黄酮提取物,在维C的共同作用下,能加速体内吸收维C。

BM同系列,还有单粒1000mg含量的产品,大家可以根据自己的需求选择。

蜂胶一直以来似乎被蒙上了一层神秘的纱,在之前的「100天百元好物推荐」中种草了一支蜂胶滴剂后,后台收到不少宝宝对蜂胶的问题私信。今天的文章就给大家简单说一说。
蜂 胶
蜂胶实际上是一种外界物质和蜂蜜自身分泌物的混合物。
蜜蜂把从植物采来的树脂类和蜡类物质,混入其上颚腺、蜡腺的分泌物,经过人工加工后形成一种有芳香气味的胶状固体物,这就形成了蜂胶。

所以蜂胶的品质,很大一部分取决于蜂蜜的质量。因为其资源稀少,蜂胶也被称作“紫色黄金”之称。它在抗菌、促进细胞再生上,有不小作用,蜂胶一直在护肤界有一定的地位。
不过从近代研究来看,蜂胶中含有一些独特的生物活性物质,这使得它在增强免疫、降血糖、降血脂、抗氧化上也有不错的效果。

澳洲品牌中有不少出蜂胶胶囊的,像Swisse、Healthy Care、Comvita都有相应的产品。
因为Comvita是专做蜂蜜相关产品的品牌,这里就简单说一说Comvita的蜂胶胶囊。

康维他的纯天然蜂胶营养胶囊属于PFL15,PFL是指蜂胶生物类黄酮标准,即每克蜂胶产品中含多少毫克的生物类黄酮。
生物类黄酮的含量是检验蜂胶浓度和品质的主要标志。
在Comvita蜂胶胶囊中,PFL15就表示,黄酮含量为15mg/g。作为日常保健,这个含量是足够的。
❗️但是!小孩、孕妇是不可以吃蜂胶胶囊的。普通成年人对增强免疫力有需求的话,每天服用2次,每次2粒就足够了。
牛 初 乳
牛初乳是专门针对提高12个月以上、免疫力偏低的宝宝的产品。
和普通牛乳不同的是,牛初乳是牛妈妈产犊后3天内的乳汁,蛋白质含量高,脂肪和糖分含量低。
牛初乳中最有效的两种成分,一是免疫球蛋白,二是乳铁蛋白,增强宝宝抵抗力主要靠免疫球蛋白,它的作用在于通过中和病菌,来提高机体抵抗力。

一般来说,牛初乳是不适合1岁以下宝宝吃的,这主要是因为目前市面上的牛初乳粉产品,在规范性和安全性上还有欠缺。
就拿杀菌过程来说,牛初乳中的成分丰富,容易受微生物污染,所以高温杀菌程序必不可少,而这一过程恰好又会造成不同程度的蛋白质损耗。为了尽可能避免损耗,加工牛初乳时则需要采用更复杂的生产工艺,这一整个过程就会降低一部分安全性。

虽然说1岁以上的宝宝,身体会形成免疫系统,但由于病原体和环境的不可控因素,有时候也很难避免完全不被感染病菌。

总的来说,牛初乳中的免疫球蛋白对增强宝宝免疫力是有积极意义的,尤其是1岁以上非母乳喂养的宝宝来说,是可以适当服用的。
市面上的牛初乳,目前有固体咀嚼片和牛初乳粉,最近风比较大的是Healthy Care的牛初乳粉

它的主要成分有:
○ 蛋白质
○ 牛初乳
○ 葡萄糖
○ 乳糖
○ 钠元素
○ 免疫球蛋白
对于1岁以上、对牛奶蛋白不过敏、有增强免疫力需求的宝宝来说,牛初乳是一个不错的选择。